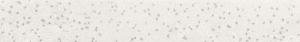
La Fabbrica Pietra Lavica Fascia Astra Arenal 7x49

La Fabbrica pietra lavica
La Fabbrica Pietra Lavica
в интернет-магазине LAROCO по цене до 13 975,00 руб.
Более 40 наименований.
Pietra Lavica можно купить on-line на сайте, позвонив по номеру +7 (812) 980-58-85 или в нашем офисе по адресу Санкт-Петербург, улица Маршала Новикова, дом № 41, корпус 1, Литер А, помещение 88/О. Для покупателей из Санкт-Петербурга специальные условия доставки.
Сортировка:
Экспресс-заказ